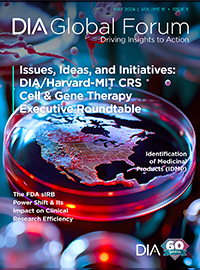
Global Forum May 2024

Menú
Get Published
DIA members gain access to a wide variety of publications. Interested in being published?
Learn the details
Global Forum Archive
DIA's digital magazine offers expert global and regional coverage of the discovery, development, regulation, surveillance, and marketing of healthcare products, including interviews with thought leaders and topical summaries from educational events.